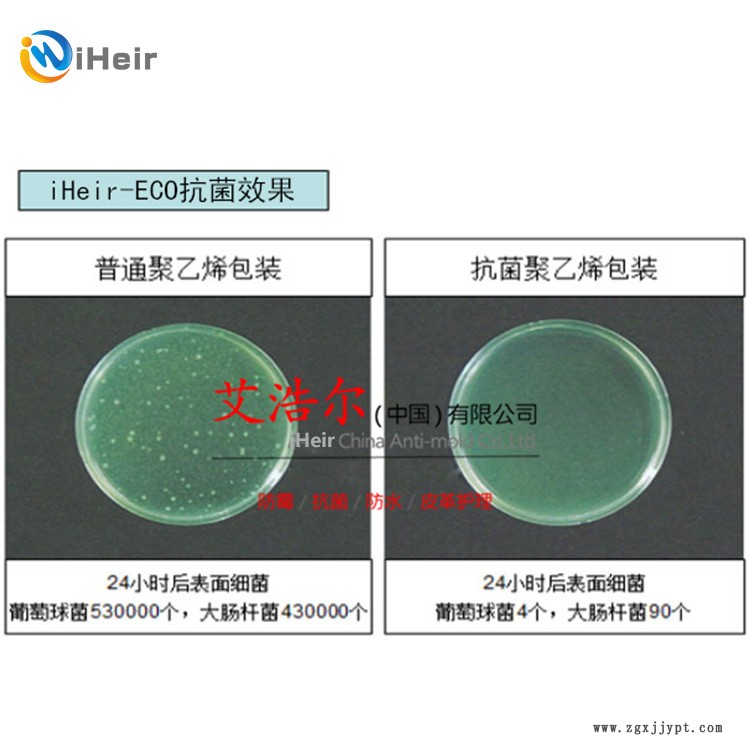

| 品牌 : | 艾浩爾/iHeir | 型號 : | iHeir-ECO |
| 外觀 : | 防霉粉 | 產品規格 : | 1kg |
| 主要用途 : | 塑料用 | 適用范圍 : | PP、PE、PET、PVC、橡膠、硅膠 |
| 產地 : | 廣州 | 廠家 : | 廣州艾浩爾 |
塑料抗菌劑iHeir-ECO
iHeir產品用于保護多種材料,免受微生物的攻擊和造成的產品退化。抗菌塑料技術并非表面應用,而是由我們的材料工程小組進行開發,直接融入到需要保護的材料中。與表面應用相比,使用這種保護方法具有諸多優勢。首先,抗菌成分均勻分布到整個受處理的部分或物體中。我們的抗菌塑料產品保護不會被磨掉,也不會干擾抗菌保護劑功能而損壞表面,即使材料剛剛接觸到表面,也仍然會對表面起到保護作用,由此形成極其耐用和強大的產品保護功能。與此相比,其他抗菌塑料技術更容易隨著時間而逐漸出現裂口和脫落。

生產抗菌塑料母料
將抗菌塑料保護融入到保護流程非常簡單。iHeir將活性抗菌成分合成到塑料母料中,然后加入到塑化流程中,并將添加劑小藥丸與普通原材料進行混合,按照正常方式制造出產品。這樣會使抗菌塑料添加劑的處理更安全,而且更容易使用。iHeir工程師使用多種材料,從塑料(聚烯烴、ABS、PS、交聯塑料 [例如尿烷、丙xi酸和聚酯]、工程樹脂 [例如 PC、軟聚氯乙烯、硅和橡膠])到粉末涂層材料,甚至是水泥狀材料(例如灌漿)。我們擁有超過 20 種不同的活性成分可供選擇,因此可以針對具體問題定制抗菌塑料解決方案,我們所出售的抗菌劑并非只有一兩種。
iHeir-ECO抗菌劑產品概述:
iHeir-ECO是一種gao效抗菌劑,在很大在范圍內通過抑止革蘭氏陽在陽性菌及革蘭氏陰性菌的生長來起到抗菌作用。它的低移動速率和高活性,使其在塑料顆粒中的抗菌性能更優越。在材料相容性和遷移速率之間保持適度平衡,使其在塑料顆粒中的抗菌性能更優越。在材料相容性和移動速率之間保持適度平衡,使iHeir-ECO適合所有普通材料。iHeir-ECO的熱穩定性可達320℃。
性 能 優 勢:
ECOFRESH是zui有效塑料抗菌劑之一, 它可防止塑料表面上的細菌的組成,而避免這些塑料表面有顏色或氣味的產生。iHeir-ECO是一種理想的產品, 可根據成品的不同要求確保達到衛生標準。它可在化妝品、牙膏和肥皂中使用,對人類和環境都很安全,美國iHeir不斷支持客戶并將產品的功效、分析方法以及毒性特征等資料提供給客戶,因此客戶受益非淺。
產品性狀:灰白色細粉末,純度 100

注意事項:
儲存使用溫度在0℃以上,使用時請配戴橡膠手套和眼罩和面具,避免直接用手去接觸浸水溶液, 避免接觸到皮膚、眼睛和粘膜,一旦接觸應立即用大量水沖洗不可延誤!
貯存:密閉、防潮、避光、保質期1年。







